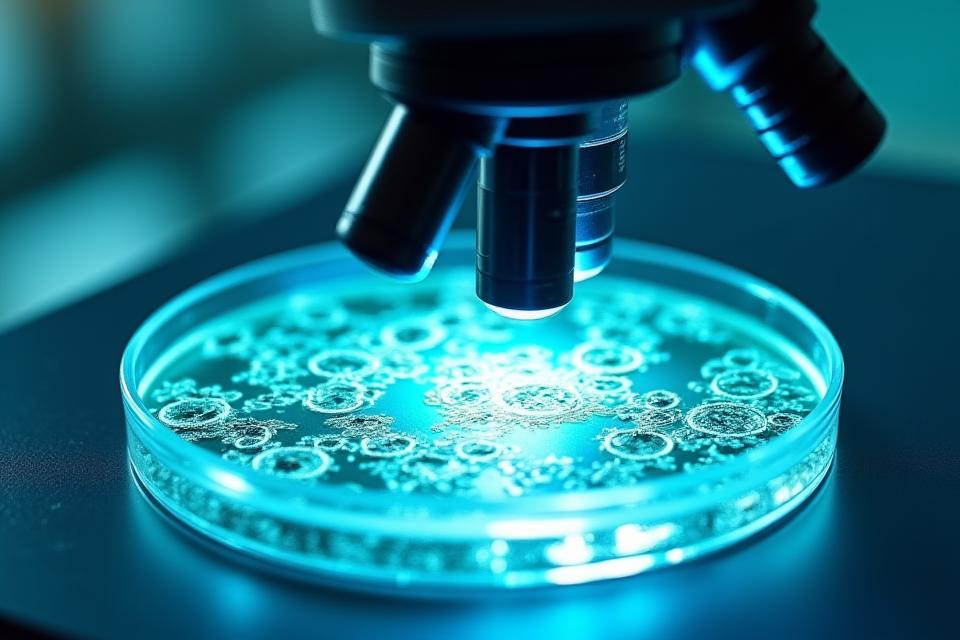
Microscope looking at cellular structures, representing breakthrough research

Expert Interviews & Insights
Get insider access to the wellness strategies that top experts use for their own healthy aging journeys. Our exclusive interviews with leading wellness researchers, longevity experts, and health practitioners provide you with cutting-edge insights and proven strategies for thriving beyond 35.
Explore Featured Interviews Discover Masterclasses
This Month's Featured Wellness Expert: Dr. Alana Reed on Cellular Longevity
Join us for an in-depth video interview with Dr. Alana Reed, a board-certified gerontologist and lead researcher at the Miami Institute for Healthy Aging. Dr. Reed shares her groundbreaking insights into cellular regeneration and optimizing metabolic health for adults over 35.
- Key Takeaways: Actionable steps for boosting cellular health.
- Member Q&A: Dr. Reed answers your most pressing questions live.
- Resources: Further reading and clinical trial information.
Meet Our Wellness Expert Network
Our network comprises over 50 board-certified physicians, acclaimed researchers, and holistic practitioners, all dedicated to empowering adults 35+ with evidence-based health guidance. Filter by specialization to find your ideal mentor.

Dr. Evelyn Chen
Nutritional Science | Metabolism
Board CertifiedSpecializing in adult metabolic health and gut microbiome optimization. Author of 'The 35+ Metabolism.'

Prof. Marcus Adams
Exercise Physiology | Strength & Mobility
Academic AffiliateFocuses on sustainable strength training and injury prevention for active adults. Leads research at UM's Sports Science center.

Dr. Priyanka Patel
Neuroscience | Stress Management
Clinical PsychologistPioneering techniques in cognitive resilience and mindfulness practices for modern adult living.

Dr. Joon Kim
Longevity Research | Biohacking
Award-Winning ResearcherAwarded for his work on epigenetics and personalized longevity protocols. Guides high-performance individuals.
Comprehensive Expert Interview Library
Dive into our extensive archive of over 100 expert interviews. Search by topic, expert, or keyword to uncover hidden gems and profound insights tailored to elevate your wellness journey.

Decoding the Mediterranean Diet for Longevity
An essential guide by Dr. Sofia Rossi on plant-based eating and anti-inflammatory benefits.
Watch Now
The Science of Deep Sleep: Beyond 40
Expert Dr. Ethan Cole reveals strategies for optimizing sleep cycles and cognitive function.
Watch Now
Mastering Mindfulness: Calm in a Chaotic World
Behavioral specialist Sarah Jenkins' guide to mitigating stress and cultivating inner peace.
Watch Now
Breaking Wellness Research & Clinical Findings
Stay ahead with exclusive early access to peer-reviewed research and clinical study findings. Our experts translate complex health science into practical applications for your everyday life, debunking myths and exploring emerging wellness technologies.
- Expert commentary on breakthrough studies.
- Practical applications for everyday living.
- Myth-busting discussions, addressing common misconceptions.
Exclusive Expert Masterclasses
Unlock deeper knowledge with our immersive masterclasses. These deep-dive sessions offer specialized learning, interactive workshops, and live Q&A with leading experts, perfect for those seeking advanced understanding and personalized guidance.

Advanced Nutrition for Cellular Health
Learn intricate dietary strategies to fuel longevity and vitality. Taught by Dr. Evelyn Chen.

Longevity Protocols: Biohacking for a Longer Life
Explore cutting-edge techniques to optimize your healthspan, led by Dr. Joon Kim.

Miami Wellness Leaders & Local Expertise
Discover the unique insights from Miami's own health and wellness pioneers. Our local experts share strategies specific to our vibrant coastal environment, from climate-adapted wellness routines to cultural health practices, and collaborations with University of Miami researchers.
- Location-specific wellness strategies.
- Insights from University of Miami collaborations.
- Local expert events and workshops.